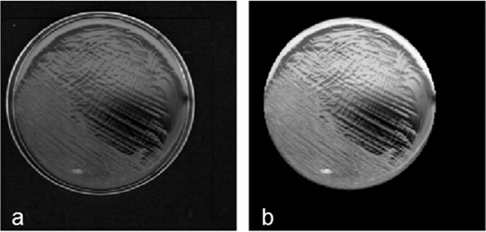
弯曲乳杆菌（L. curvatus）样本在分割前（a）与分割后（b）的平均强度灰度图像

光谱侦探:用近红外与中红外技术'看'见食品中的隐形细菌威胁
发布时间:2025-09-15 浏览次数:186 分享:
食品微生物安全是公共卫生领域的重要课题,特别是即食肉制品如切片熟火腿的微生物污染问题备受关注。传统细菌检测方法(如ISO 15214:1998)依赖培养技术,存在耗时长(通常需要2-5天)、成本高、检测限不理想等固有缺陷。乳酸菌(LAB)中的L. curvatus和L. sakei是导致熟火腿酸败、黏液分泌等变质现象的主要菌种,亟需开发快速准确的检测手段。近年来,光谱技术因其快速、无损的特点在食品安全领域展现出巨大潜力。本研究创新性地将宏观超光谱扫描(NIR 10,470-5,880 cm⁻¹)、FT-NIR分光光度(12,500-5,800 cm⁻¹)和FT-MIR显微镜(4,000-675 cm⁻¹)三种技术联用,通过主成分分析(PCA)等化学计量学方法(如Figure 1所示),系统评估了它们在简单基质(MRS琼脂培养基)和复杂食品(熟火腿)中的检测效能。特别开发的超光谱图算法,成功将三维图像数据压缩为一维特征信号,大幅提升了分析效率。
技术方法创新:
研究团队设计了三层次检测体系:宏观尺度的NIR超光谱成像(空间分辨率0.47mm)、常规FT-NIR光谱和微观FT-MIR成像(检测区域100×100μm²)。在数据处理方面,首次将"超光谱图"概念引入微生物检测领域,通过合并PCA得分、Q残差、T²和载荷向量的频率分布曲线,将单幅图像信息压缩为特征信号。

Figure 1 从培养皿图像中获得的三个平均高光谱图(对应琼脂凝胶、弯曲乳杆菌和清酒乳杆菌类别)与信号各部分的来源描述一并呈现。本案例采用列均值中心化作为预处理后,选取了5个主成分的模型进行分析。
1. FT-NIR光谱分析结果
在凝胶培养物上,FT-NIR光谱能够区分三种样品类型,特别是在波数高于7,500 cm⁻¹的区域。使用不同背景(空玻璃培养皿E系列和含凝胶的聚丙烯培养皿G系列)采集的信号显示出明显差异(如Figure 2所示)。然而,在人工污染的熟火腿样品上,FT-NIR测量未能有效检测细菌存在,这可能是由于FT-NIR测量的灵敏度相对较低,且火腿的吸收波段可能掩盖了LAB的信号。

Figure 2 E系列(a)和G系列(b)的得分图。白色符号代表凝胶样品,红色代表弯曲乳杆菌(L. curvatus),蓝色代表清酒乳杆菌(L. sakei);三角形和圆形用于区分分析时段
2. NIR超光谱成像结果:
超光谱图像通过PCA处理后,能够清晰区分培养皿样品和背景像素。在评估的预处理方法组合中,去趋势处理结合列均值中心化能最优区分培养皿对应的像素簇与背景像素形成的簇群。所有样本图像的得分图像表明,第二主成分(PC2)可清晰区分培养皿与背景区域(如Figure 3所示)。通过将图像转换为"超光谱图",研究人员成功将每幅图像的信息压缩为单一信号,便于后续分析。体系在保证高灵敏度的同时,实现了试剂用量的最小化,降低了检测成本。与FT-NIR结果类似,超光谱成像技术也无法在熟火腿样品上检测到细菌污染,原因可能包括仪器未覆盖整个NIR光谱范围以及细菌浓度过低。
Figure 3 弯曲乳杆菌(L. curvatus)样本在分割前(a)与分割后(b)的平均强度灰度图像。
3. FT-MIR显微光谱分析结果
FT-MIR显微镜在微观尺度上工作,能够获得与细菌相关的小区域光谱,从而最大化细菌信号相对于基质的贡献。在凝胶培养物上,FT-MIR反射吸收光谱(RAS)能够清晰区分两种乳酸菌。更重要的是,FT-MIR技术成功在人工污染的熟火腿样品上检测并识别了细菌种类,主要依靠酯类(约1740 cm⁻¹)和酰胺(约1620 cm⁻¹)波段作为标记物(如Figure 4所示)。

Figure 4 L. curvatus(红色得分)和 L. sakei(蓝色得分)在琼脂凝胶上记录的FT-MIR RAS光谱的PC1–PC3得分图(a)与载荷图(b)。
本研究系统验证了光谱成像技术在食品细菌检测中的应用潜力,得出三个关键结论:首先,在简单基质(MRS琼脂培养基)中,NIR、FT-NIR和FT-MIR三种技术均能有效区分L. curvatus和L. sakei,其中FT-MIR显微镜凭借1740 cm⁻¹(酯类)和1620 cm⁻¹(酰胺)特征峰实现最精确识别;其次,开发的超光谱图算法通过压缩三维图像数据为一维特征信号,大幅提升了分析效率,为批量处理食品样品提供了新思路;最后,在复杂食品基质(熟火腿)中,仅FT-MIR突破基质干扰成功检测细菌,证实其在真实场景中的独特优势。本研究成果可沿三个方向推进产业化:一是构建分级检测系统,将FT-NIR(10秒/样本)用于产线快速初筛,配合FT-MIR显微镜(检测限10⁴ CFU/cm²)进行确认,形成完整的"筛查-确认"链条;二是开发基于特征波段的微型传感器,通过聚焦1740/1620 cm⁻¹等关键标识区域,降低设备成本和体积;三是结合人工智能技术,将超光谱图算法与深度学习结合,建立覆盖常见食源性致病菌的光谱数据库。特别值得注意的是,FT-MIR在熟火腿中的成功应用,为即食肉制品的在线质控提供了直接技术支撑。
原文doi:https://doi.org/10.1016/j.talanta.2016.02.059
来源:微生物安全与健康网,作者~雷晓旭。
